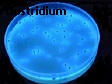
clostridium

Welcome to our website!
A group of South African Laboratories

Visit our Chemistry Testing Laboratories, celebrating our 25 Years Service in Excellence to Industry! Visit our Microbiology Testing Laboratories, where Good Quality Service is a lasting impression!
About us
We are proudly one of the very few solely independent South African companies still in business today. We are, at present implementing ISO 9001.
Please support us! We are small, but expanding and are a SANAS accredited ISO/IEC 17025 Testing and Consulting Laboratory.
We provide a wide range of laboratory and scientific services such as bacteriology and chemical testing of foodstuffs, waters, beverages, agricultural commodities, petroleum products and consumer products.

The business was started in a garage in 1989, at the Durban North home of Vic Soffiantini, an experienced and qualified Analytical Chemist. His experience covered working in labotratories in fertilizers, chemicals, sugar and dairy industries; as well as various consulting and contract laboratories.
In 1990 the business was incorporated as a Close Corporation. During 1991 it moved to bigger premises at John Ross House in the Durban CBD. During this time period many science students did their successful inservice training with the Company.
In 1995 the business had outgrown its premises in the CBD and moved south of Durban to Francois Road near the busy harbour industrial area.
The laboratories soon outgrew these premises as well. In 2004 the Laboratories moved into larger premises around the corner in Umbilo Road.
Chem-Science Laboratories cc had basically two laboratories, one Chemical and the other Microbiology. In March 2003, the Microbiology Laboratory broke away from Chem-Science Laboratories cc and became a separate legal entity known as Bio-Science Technologies (Pty) Ltd.
Due to rapid expansion and an ever growing loyal client base, it became necessary to upgrade the legal identity of the small business, Chem-Science Laboratories cc; so in 2012 it became a fully established (Pty) Ltd company.
To date Chem-Science Laboratories (Pty) Ltd has trained well over 70 students; helping to establish a competent base of future technologists and scientists for South African industries and research laboratories.